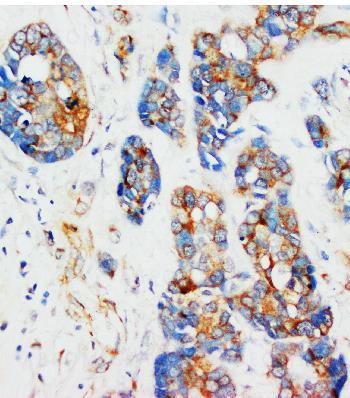

Anti-alpha-Tubulin Monoclonal Antibody (Clone: DM1A)
Figure 1: Anti-alpha-Tubulin antibody(monoclonal) 39-1057. IHC(P): Human Mammary Cancer Tissue.
Roll over image to zoom in
Shipping Info:
For estimated delivery dates, please contact us at [email protected]
Amount : | 100 μg/vial |
Isotype : | Mouse IgG1 |
Purification : | Ascites |
Content : | Mouse ascites fluid, 1.2% sodium acetate, 2mg BSA, with 0.01mg NaN3 as preservative. Reconstitute : Add 1ml of PBS buffer will yield a concentration of 100ug/ml. |
Storage condition : | At -20˚C for one year. After reconstitution, at 4˚C for one month. It can also be aliquotted and stored frozen at -20˚C for a longer time. Avoid repeated freezing and thawing. |
Alpha-tubulin(b-alpha-1) mRNA is expressed only in brain with a molecular weight of about 55,000. The 3-prime UTR of b-alpha-1 is more than 80% homologous to the UTR of the rat brain alpha-tubulin gene, IL-alpha-T1. B-alpha-1 encodes a predicted 451-amino acid protein that is 100% identical to the rat homolog and differs by only 2 and 3 amino acids from the pig and chicken homologs, respectively.
Western blot : 2μg/ml; Immunohistochemistry(Paraffin-embedded Section) : 1-2μg/ml
For Research Use Only. Not for use in diagnostic/therapeutics procedures.
Subcellular location: | Cytoplasm |
Post transnational modification: | Detyrosinated tubulin alpha-1A chain: Detyrosination is involved in metaphase plate congression by guiding chromosomes during mitosis: detyrosination promotes interaction with CENPE, promoting pole-proximal transport of chromosomes toward the equator (PubMed:25908662). Detyrosination increases microtubules-dependent mechanotransduction in dystrophic cardiac and skeletal muscle. In cardiomyocytes, detyrosinated microtubules are required to resist to contractile compression during contraction: detyrosination promotes association with desmin (DES) at force-generating sarcomeres, leading to buckled microtubules and mechanical resistance to contraction (By similarity). |
Tissue Specificity: | Expressed at a high level in fetal brain. |
BioGrid: | 113603. 261 interactions. |
There are currently no product reviews
|